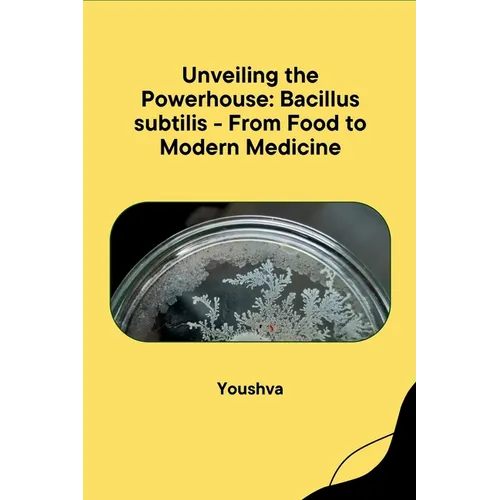
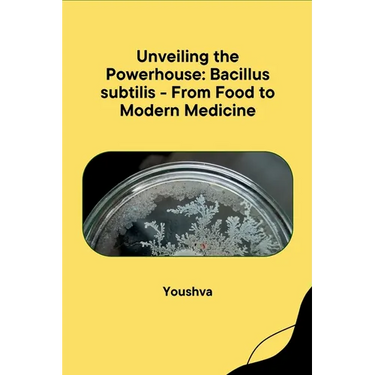

Unveiling the Powerhouse: Bacillus subtilis - From Food to Modern Medicine - Paperback
 Unveiling the Powerhouse: Bacillus subtilis - From Food to Modern Medicine - Paperback
$36.05
/
Unveiling the Powerhouse: Bacillus subtilis - From Food to Modern Medicine - Paperback
$36.05
/

Your payment information is processed securely. We do not store credit card details nor have access to your credit card information.
by Yousshva (Author)
"Unveiling the Powerhouse: Bacillus subtilis - From Food to Modern Medicine" dives into the world of Bacillus subtilis, a seemingly ordinary bacterium with extraordinary applications. This book unveils its hidden potential, exploring its role in fermenting foods like yogurt and kimchi. It then delves into its use in cutting-edge medical fields, potentially offering solutions for antibiotic resistance and even holding promise for future advancements. By exploring both traditional and novel uses of Bacillus subtilis, this book unveils a powerhouse microbe shaping our food and health.